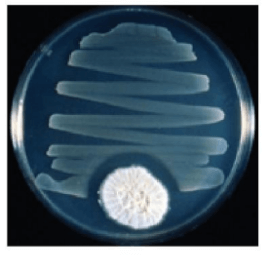

Mở đầu
Câu hỏi SGK Sinh 10 Kết nối tri thức Bài 20 (trang 116): Vệt màu khổng lồ trên vùng biển Ireland (H.a), màu hồng đỏ của Laguna Salada de Torrevieja thuộc Tây Ban Nha (H.b), bãi biển phát sáng ở vịnh Jervis ở Australia (H.c) hay màu xanh đặc trưng của Hồ Gươm ở Việt Nam (H.d) dưới đây, tất cả đều được tạo thành từ hàng nghìn tỉ sinh vật nhỏ bé không thể nhìn thấy bằng mắt thường có tên gọi chung là vi sinh vật. Vậy vi sinh vật là gì? Với kích thước vô cùng nhỏ bé như vậy thì “thức ăn” của chúng là gì và chúng ta làm thế nào để có thể nghiên cứu về chúng?

Trả lời:
– Vi sinh vật là những sinh vật kích thước nhỏ bé, thường chỉ quan sát được dưới kính hiển vi.
– Thức ăn của vi sinh vật rất đa dạng phụ thuộc vào tùy từng loài:
+ Có loài “ăn” các chất hữu, vô cơ bé nhỏ bằng cách hấp thụ chúng qua màng tế bào, các muối khoáng và nước cũng được thẩm thấu qua màng tế bào.
+ Có loài hấp thu các chất vô cơ của môi trường để tự tổng hợp lên chất hữu cơ của cơ thể, có loài sử dụng các chất hữu cơ có sẵn trong thức ăn (vụn hữu cơ, các vi sinh vật khác,…) để tổng hợp nên chất hữu cơ của cơ thể.
+ Có loài sống kí sinh vào các tế bào khác (tế bào vi khuẩn/tế bào thực vật/tế bào người hay động vật), sử dụng các dinh dưỡng, nguyên liệu cần thiết có sẵn trong tế bào vật chủ để sinh sản, phát triển.
– Để nghiên cứu vi sinh vật, người ta thường sử dụng các phương pháp như phương pháp quan sát dưới kính hiển vi (soi tươi, nhuộm đơn, nhuộm Gram), phương pháp phân lập và nuôi cấy vi sinh vật.
I. Các nhóm vi sinh vật
Dừng lại và suy ngẫm
Câu hỏi 1 SGK Sinh 10 Kết nối tri thức Bài 20 (trang 118): Vi sinh vật là gì? Quan sát hình 20.1, kể tên các nhóm vi sinh vật.

Trả lời:
– Vi sinh vật là những sinh vật có kích thước nhỏ bé, thường chỉ quan sát được dưới kính hiển vi.
– Các nhóm vi sinh vật:
+ Vi sinh vật nhân thực: Nấm đơn bào, tảo đơn bào, động vật nguyên sinh và các vi nấm, vi tảo và động vật đa bào kích thước hiển vi.
+ Vi sinh vật nhân sơ: Archaea (vi sinh vật cổ) và vi khuẩn.
Câu hỏi 2 SGK Sinh 10 Kết nối tri thức Bài 20 (trang 118): Giải thích vì sao vi sinh vật có tốc độ trao đổi chất nhanh, sinh trưởng, sinh sản nhanh hơn so với thực vật và động vật.
Trả lời:
– Vi sinh vật có tốc độ trao đổi nhanh, sinh trưởng và sinh sản nhanh hơn so với thực vật và động vật là bởi vì kích thước của vi sinh vật rất nhỏ, đo đó cấu tạo của chúng cũng đơn giản hơn cho với thực vật và động vật dẫn đến khả năng trao đổi chất với môi trường nhanh, đáp ứng nhu cầu về vật chất và năng lượng để vi sinh vật sinh trưởng, sinh sản.
II. Các kiểu dinh dưỡng của vi sinh vật
Dừng lại và suy ngẫm
Câu hỏi 1 SGK Sinh 10 Kết nối tri thức Bài 20 (trang 118): Đọc bảng 20, phân biệt các kiểu dinh dưỡng ở vi sinh vật. So với thực vật và động vật, vi sinh vật có thêm những kiểu dinh dưỡng nào?

Trả lời:
– Các kiểu dinh dưỡng ở vi sinh vật:
– So với động vật và thực vật thì vi sinh vật có thêm 2 kiểu dinh dưỡng là hóa tự dưỡng và quang dị dưỡng. Động vật chủ yếu là sinh vật dị dưỡng, còn thực vật chủ yếu là sinh vật quang tự dưỡng.
Câu hỏi 2 SGK Sinh 10 Kết nối tri thức Bài 20 (trang 118): Vi sinh vật có phạm vi phân bố rộng hơn rất nhiều so với những nhóm sinh vật khác nhờ đặc điểm nào? Giải thích
Trả lời:
– So với những nhóm sinh vật khác, vi sinh vật có phạm vi phân bố rộng hơn là do chúng có kích thước nhỏ, cấu tạo cơ thể đơn giản đồng thời tốc độ trao đổi chất nhanh, sinh trưởng và sinh sản nhanh có nhiều kiểu chuyển hoá vật chất và năng lượng nên có thể thích nghi với nhiều kiểu môi trường, kể cả điều kiện khắc nghiệt.
III. Một số phương pháp nghiên cứu vi sinh vật
Dừng lại và suy ngẫm
Câu hỏi 1 SGK Sinh 10 Kết nối tri thức Bài 20 (trang 121): Làm thế nào có thể phân loại được các vi sinh vật trong khi chúng ta không nhìn thấy chúng bằng mắt thường?
Trả lời:
– Với các vi sinh vật không nhìn thấy chúng bằng mắt thường, chúng ta có thể dùng một số phương pháp để phân loại như sau:
+ Sử dụng kính hiển vi quang học, kính hiển vi điện tử: Đối với kích thước nhỏ hơn như nấm đơn bào, tảo đơn bào, vi nấm, vi tảo, vi khuẩn
+ Sử dụng kính lúp: Đối với một số vi sinh vật nhân thực như động vật nguyên sinh
+ Sử phương pháp phân lập và nuôi cấy vi sinh vật: Trên môi trường đặc, mỗi tế bào vi khuẩn phát triển tạo thành một khuẩn lạc. Có thể căn cứ vào kích thước, hình dạng của khuẩn lạc để phân loại các vi khuẩn.
Câu hỏi 2 SGK Sinh 10 Kết nối tri thức Bài 20 (trang 121): Quan sát cấu tạo thành tế bào vi khuẩn Gr – và vi khuẩn Gr + ở hình 7.3, hãy giải thích vì sao hai loại vi khuẩn này lại bắt màu khác nhau khi nhuộm Gram.
Trả lời:
- Vi khuẩn Gram dương có thành tế bào được cấu tạo chủ yếu từ peptidoglycan (lớp peptidoglycan dày). Các lớp dày peptidoglycan là nguyên nhân khiến cho vi khuẩn Gram dương có thể giữ lại hầu hết chất nhuộm tím trong quá trình nhuộm, khiến chúng có màu tím.
- Trong khi đó, vi khuẩn Gram âm có thành tế bào gồm một lớp mỏng peptidoglycan và màng ngoài có lipopolysaccharid không có ở vi khuẩn Gram dương. Vì lớp peptidoglycan mỏng nên lớp này không giữ lại chất nhuộm tím của thuốc nhuộm ban đầu mà tạo ra màu đỏ trong quá trình nhuộm Gram.
Luyện tập và Vận dụng
Câu hỏi 1 SGK Sinh 10 Kết nối tri thức Bài 20 (trang 121): Một loại vi khuẩn chỉ cần amino acid loại methionine làm chất dinh dưỡng hữu cơ và sống trong hang động không có ánh sáng. Cho biết kiểu dinh dưỡng của vi khuẩn này và giải thích.
Trả lời:
- Vi khuẩn chỉ cần amino acid loại methionine làm chất dinh dưỡng hữu cơ và sống trong hang động không có ánh sáng thì kiều dinh dưỡng của vi khuẩn này hoá dị dưỡng vì khuẩn này chỉ sử dụng chất dinh dưỡng hữu cơ là nguồn năng lượng và nguồn carbon để duy trì sự sống.
Câu hỏi 2 SGK Sinh 10 Kết nối tri thức Bài 20 (trang 121): Hình dưới có hai loài vi khuẩn, một loài mọc tạo thành khuẩn lạc to, trắng và một loài mọc thành những đường ziczac. Tuy nhiên, xung quanh khuẩn lạc to lại xuất hiện một vòng trong (gọi là vòng vô khuẩn). Em hãy giải thích hiện tượng trên.
Trả lời:
– Xung quanh khuẩn lạc to xuất hiện một vòng trong (gọi là vòng vô khuẩn) do loại vi khuẩn có khuẩn lạc to tròn, trắng đã tiết ra chất ức chế kìm hãm sự phát triển của loại vi khuẩn mà khuẩn lạc mọc ziczac. Vì vậy mà xung quanh khuẩn lạc của vi khuẩn tròn, khuẩn lạc của vi khuẩn ziczac không mọc được, nên ta mới thấy hiện tượng vòng vô khuẩn màu trong suốt.
Câu hỏi 3 SGK Sinh 10 Kết nối tri thức Bài 20 (trang 121): Theo chẩn đoán ban đầu của bác sĩ, một người bị bệnh nhiễm khuẩn phổi. Theo em, bác sĩ sẽ ra chỉ định gì tiếp theo để có thể kê đơn thuốc chính xác giúp người này mau khỏi bệnh?
Trả lời:
– Bác sĩ sẽ chỉ định bệnh nhân:
+ Chụp X-quang phổi: X-quang phổi giúp chẩn đoán viêm phổi.
+ Xét nghiệm máu: Kiểm tra tình trạng nhiễm khuẩn phổi thông qua số lượng hồng cầu.
+ Nuôi cấy đờm: Để tìm vi khuẩn gây bệnh, từ đó xác định khả năng kháng thuốc, nhạy cảm thuốc của vi khuẩn (kháng sinh đồ), làm cơ sở kê đơn kháng sinh tiếp theo.
=> Từ kết quả xét nghiệm loại vi khuẩn, bác sĩ sẽ kê đơn thuốc kháng sinh dựa vào hiệu quả của các loại kháng sinh đối với loại vi khuẩn đó cũng như tình trạng sức khỏe của bệnh nhân.